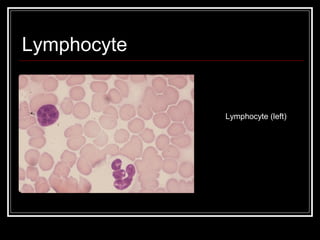
Lymphocyte
Lymphocyte (left)

Blood transports oxygen, nutrients, waste, hormones, and other essential elements throughout the body. It is composed of plasma and formed elements including red blood cells, white blood cells, and platelets. Red blood cells carry oxygen, white blood cells fight infection, and platelets help with clotting. Blood is vital for life as it delivers oxygen and removes carbon dioxide from tissues while also transporting nutrients, hormones, and waste products.